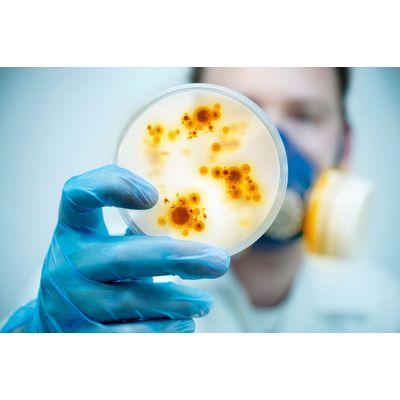

- Home
- Companies
- Lubron UK Limited
- Products
- Lubron - Granular Activated Carbon ...
Lubron - Granular Activated Carbon Filtration
Activated Carbon is effective for the removal of Chlorine and Organics which can damage and foul Ion Exchange resin and Reverse Osmosis membranes. Activated Carbon has the highest volume of adsorbing porosity, of any material known to mankind. It can be made from a number of substances containing a high carbon content such as coal, coconut shells and wood. Carbon filter systems come in the form of cartridge filters or backwashable filters, both have limited lifespan with the latter lasting the longest before needing to be replaced, because it can be automatically backwashed at timed intervals.
Chlorine has been used for many years to disinfect drinking water, where it is very effective in killing a large variety of water-borne pathogens including those that can cause Typhoid, Dysentery, Cholera and Legionnaires disease. Regional water authorities add chlorine to drinking water in huge contact tanks, using high levels of chlorine at the inlet to ensure complete inactivation of Bacteria and Virus’. As the water moves through the tank to the outlet, the Chlorine reacts with the pathogens and other contaminants in the water and is reduced to a much lower level before exiting the water treatment works. This low level residual chlorine helps to keep distribution pipes clear of bacterial growth, however it is at a low enough level to not cause harm to humans.
Although the residual level of Chlorine in drinking water is harmless to humans, it can quickly cause costly irreversible damage to many types of water treatment equipment including Water Softener resin and Reverse Osmosis membranes. This damage will lead to hard water passing through water softeners, and increased levels of impurities in RO water which will cause further damage to process equipment fed by these systems.
Activated Carbon can reduce harmful Chlorine to its less harmful, negatively charged anionic form Chloride, protecting Ion Exchange resin and Reverse Osmosis membranes from damage.
Activate Carbon is also highly porous, with a huge surface area which can adsorb organics, preventing biological fouling.
Lubron sell a large range of Activated Carbon filter systems, from small carbon block filters to larger backwashable systems.
